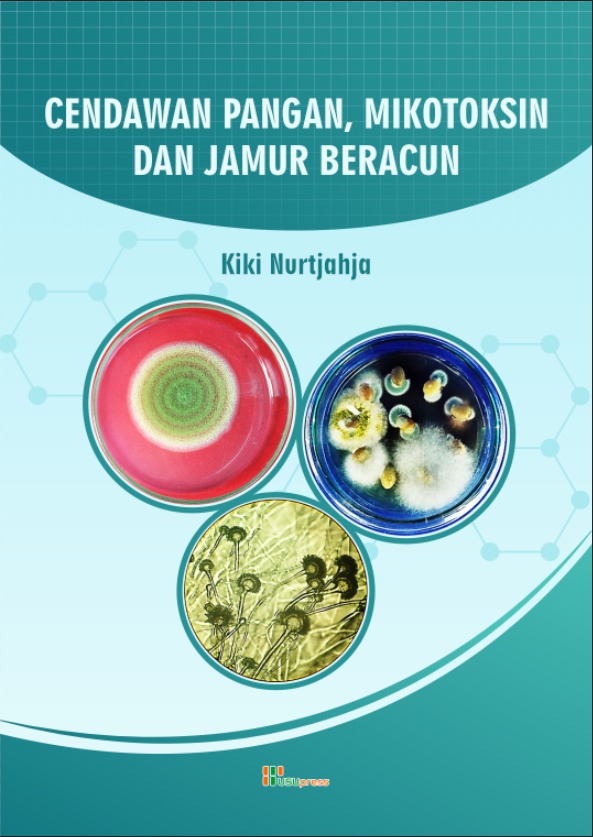
Cendawan Pangan, Mikotoksin dan Jamur Beracun

We Preserve Your Thoughts.......
Terbitan Terbaru
by
Home Energy Management System hadir sebagai solusi...
by
Sengketa pertanahan merupakan persoalan kl...
by
Buku ini disusun sebagai bahan ajar yang ditujukan...
by
Pada buku ini dibahas peran cendawan sebagai bah...